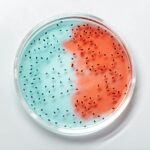
Close-up of vibrant blue and red bacteria cultures in a petri dish.

Beschreibung
Die frühe Syphilis ist ein kritisches Stadium der sexuell übertragbaren Infektion (STI) Syphilis, das die primäre Syphilis, die sekundäre Syphilis und die frühe latente Syphilis umfasst. Sie wird durch das Bakterium Treponema pallidum verursacht und hauptsächlich durch sexuellen Kontakt übertragen. In diesem frühen Stadium ist die Infektion hochansteckend, sodass eine rechtzeitige Diagnose und angemessene Behandlung unerlässlich sind, um weitere Komplikationen zu vermeiden. Die primäre Syphilis äußert sich durch schmerzlose Geschwüre, meist an den Genitalien, im Mund oder im Enddarm, während die sekundäre Syphilis mit einem Hautausschlag an Händen, Füßen oder am Körper sowie Fieber, Müdigkeit und geschwollenen Lymphknoten einhergeht. Die frühe latente Syphilis zeigt keine sichtbaren Symptome, aber die Infektion bleibt innerhalb des ersten Jahres nach dem primären und sekundären Stadium bestehen.
Syphilis hat einen komplexen historischen Hintergrund, mit dokumentierten Fällen, die Jahrhunderte zurückreichen. Während konzertierte Anstrengungen im 20. Jahrhundert zu einem Rückgang der gemeldeten Fälle führten, ist in den letzten Jahren ein besorgniserregendes Wiederauftreten der Syphilis zu beobachten. Der Anstieg der Infektionen, insbesondere in bestimmten Risikogruppen, erfordert eine kontinuierliche Überwachung und Initiativen im Bereich der öffentlichen Gesundheit, um die Ausbreitung einzudämmen.
Ohne angemessene Behandlung kann die frühe Syphilis in das latente Stadium übergehen und zu schweren Komplikationen führen, die verschiedene Organe betreffen. Mögliche Folgen sind neurologische Probleme, Herz-Kreislauf-Erkrankungen und Schädigungen der Augen. Eine rechtzeitige Diagnose und Behandlung sind entscheidend, um diese langfristigen Gesundheitsrisiken zu vermeiden.
Die Diagnose einer frühen Syphilis umfasst eine klinische Untersuchung und spezifische Labortests, darunter serologische Tests zum Nachweis von Antikörpern gegen Treponema pallidum. Zusätzlich können Proben aus dem Schanker oder verdächtigen Läsionen untersucht werden. Glücklicherweise kann eine frühe Syphilis wirksam mit Antibiotika, vor allem Penicillin, behandelt werden, wodurch die Infektion beseitigt und das Fortschreiten der Krankheit gestoppt werden kann.
Die Syphilis wird in erster Linie durch sexuellen Kontakt übertragen, einschließlich Vaginal-, Anal- und Oralsex. Ungeschützter Sex und mehrere Sexualpartner erhöhen das Risiko, sich mit der Infektion anzustecken. Schwangere Frauen mit Syphilis können die Krankheit auch auf ihr ungeborenes Kind übertragen, was zu einer angeborenen Syphilis führt.
Zur Vorbeugung einer frühen Syphilis gehört Safer Sex, einschließlich der konsequenten und korrekten Verwendung von Kondomen. Regelmäßige Tests für sexuell aktive Personen, insbesondere für Personen mit mehreren Partnern oder mit risikoreichem Verhalten, sind unerlässlich. Maßnahmen im Bereich der öffentlichen Gesundheit, darunter Aufklärungskampagnen und Partnerbenachrichtigungsprogramme, spielen eine entscheidende Rolle bei der Eindämmung der Ausbreitung der Syphilis.
Die biologischen Hintergründe
Die frühe Syphilis befällt in erster Linie die Schleimhäute und die Haut und führt zu erheblichen Störungen ihrer normalen Funktion. Die Schleimhäute kleiden den Genitaltrakt, den Mund und den Enddarm aus und haben die wichtige Aufgabe, Schleim zu produzieren, eine schützende Flüssigkeit, die diese Oberflächen befeuchtet und schmiert und so den reibungslosen Transport von Substanzen unterstützt.
In einem gesunden Zustand fungieren die Schleimhäute als wichtige Abwehrbarriere, die das Eindringen von Krankheitserregern und fremden Eindringlingen verhindert. Sie enthalten auch Immunzellen, die dabei helfen, potenzielle Bedrohungen zu identifizieren und zu neutralisieren, und so zur Immunantwort des Körpers beitragen.
Wenn jedoch eine frühe Syphilis den Körper befällt, dringt das Bakterium Treponema pallidum bei sexuellem Kontakt über die Schleimhäute ein. Die Infektion beginnt mit der Bildung schmerzloser Schorfgeschwüre, die als Eintrittspforten für den Erreger dienen. Das Bakterium ist sehr geschickt darin, das Immunsystem zu umgehen, sodass es sich im Körper vermehren und ausbreiten kann.
Im weiteren Verlauf der Infektion, der sekundären Syphilis, verbreitet sich Treponema pallidum über die Blutbahn und das Lymphsystem und befällt verschiedene Organe und Gewebe. Auch die Haut ist betroffen, was zu dem für dieses Stadium charakteristischen Hautausschlag führt. Die durch die Infektion ausgelöste Immunreaktion kann Entzündungen verursachen, die zu Hautausschlägen an den Handflächen, Fußsohlen und anderen Körperstellen führen.
Die Schädigung der Schleimhäute und der Haut im Frühstadium der Syphilis erleichtert dem Bakterium den Zugang zum Körperinneren, wodurch es für das Immunsystem schwierig wird, die Infektion zu bekämpfen. Darüber hinaus erschwert die Fähigkeit der Bakterien, sich der Erkennung zu entziehen, die natürlichen Abwehrmechanismen des Körpers zusätzlich. Dieses komplexe Zusammenspiel zwischen Treponema pallidum und den Abwehrkräften des Körpers treibt das Fortschreiten der frühen Syphilis voran und unterstreicht die Bedeutung einer frühzeitigen Diagnose und Behandlung, um weitere Komplikationen zu vermeiden.
Arten und Symptome
Die frühe Syphilis verläuft in drei verschiedenen Stadien: Primäre Syphilis, Sekundäre Syphilis und frühe latente Syphilis. Jedes Stadium weist einzigartige Symptome und Erscheinungsformen auf, die die Diagnose und Behandlung der Krankheit erleichtern.
1. Primäre Syphilis:
Die primäre Syphilis ist das Anfangsstadium der Infektion und zeichnet sich durch das Auftreten von schmerzlosen, runden Geschwüren aus, die als Schanker bezeichnet werden. Diese Schanker entwickeln sich typischerweise an der Infektionsstelle, z. B. an den Genitalien, im Mund, im Rektum oder, bei primären Läsionen im Analbereich, im Analbereich. Schanker sind hochansteckend und dienen als wichtiger Übertragungsweg auf andere Personen bei sexuellem Kontakt. Unbehandelt können Schanker mehrere Wochen bestehen bleiben, bevor sie spontan abheilen.
Sekundäre Syphilis:
Innerhalb weniger Wochen bis Monate nach dem Auftreten der Schanker wird die sekundäre Syphilis sichtbar. In diesem Stadium verbreitet sich das Bakterium Treponema pallidum über die Blutbahn und das Lymphsystem im gesamten Körper und führt zu einer Vielzahl von Symptomen. Neben dem typischen Hautausschlag an den Handflächen, Fußsohlen und anderen Körperteilen können bei Personen mit primären Läsionen im Analbereich Läsionen im Analbereich auftreten. Die sekundäre Syphilis kann auch zu grippeähnlichen Symptomen wie Fieber, Müdigkeit, Halsschmerzen und geschwollenen Lymphknoten führen. Weitere Begleiterscheinungen sind fleckiger Haarausfall, Schleimhautläsionen und Gewichtsverlust.
Frühe latente Syphilis:
Nach der primären und sekundären Syphilis tritt die frühe latente Syphilis auf, in der keine sichtbaren Symptome auftreten. Die Infektion bleibt jedoch im Körper latent vorhanden. Es ist wichtig zu beachten, dass die frühe latente Syphilis nicht speziell auf primäre Läsionen im Analbereich bei Syphilis bezieht, sondern die allgemeine Phase der asymptomatischen Infektion umfasst, die innerhalb des ersten Jahres nach der primären und sekundären Syphilis auftritt.
Das Verständnis der verschiedenen Arten und Symptome der frühen Syphilis ist für ihre Früherkennung und richtige Behandlung von entscheidender Bedeutung. Eine schnelle Diagnose und geeignete Behandlung, oft mit Antibiotika wie Penicillin, kann die Infektion wirksam heilen und ein weiteres Fortschreiten der Krankheit verhindern.
Untersuchung und Diagnostik
Die Diagnose der frühen Syphilis erfordert einen umfassenden Ansatz, der eine klinische Untersuchung mit spezifischen Labortests und bildgebenden Verfahren kombiniert. Eine rechtzeitige und genaue Diagnose ist unerlässlich, um eine schnelle Behandlung einzuleiten und weitere Komplikationen zu vermeiden.
Klinische Untersuchung:
Der erste Schritt zur Diagnose einer frühen Syphilis ist eine gründliche klinische Untersuchung, die eine detaillierte Anamnese und eine körperliche Untersuchung umfasst. Während der Anamnese wird der Arzt Fragen zu den auftretenden Symptomen, den letzten sexuellen Aktivitäten, früheren sexuell übertragbaren Infektionen und einer möglichen Exposition gegenüber Syphilis stellen. Es ist wichtig, alle relevanten Informationen anzugeben, um eine genaue Diagnose zu ermöglichen.
Die körperliche Untersuchung umfasst die Untersuchung des Körpers auf sichtbare Anzeichen einer Syphilis, wie z. B. das Vorhandensein von Schorf oder Hautausschlag. Besondere Aufmerksamkeit wird den Genitalien, dem Mund und dem Rektum gewidmet, da dies häufige Stellen für primäre Syphilis-Schorf sind. Zusätzlich kann der Arzt die Haut auf sekundäre Syphilis-Hautausschläge untersuchen, einschließlich etwaiger Läsionen oder Schleimhautbefall.
Labortests und Bildgebung:
Mehrere Labortests spielen eine wichtige Rolle bei der Bestätigung der Diagnose einer frühen Syphilis.
● Nicht-treponemale Tests: Diese Tests, darunter der Venereal Disease Research Laboratory (VDRL)-Test und der Rapid Plasma Reagin (RPR)-Test, weisen unspezifische Antikörper nach, die als Reaktion auf eine Syphilis-Infektion gebildet werden. Ein positives Ergebnis weist auf das Vorhandensein von Syphilis-Antikörpern hin, jedoch ist eine weitere Bestätigung erforderlich.
● Treponemale Tests: Bestätigungstests wie der Treponema pallidum Particle Agglutination Assay (TPPA) und der Fluorescent Treponemal Antibody Absorption (FTA-ABS) Test weisen spezifisch Antikörper gegen Treponema pallidum nach und bestätigen damit eine Syphilis-Infektion.
● Analyse der Cerebrospinalflüssigkeit (CSF): Bei Verdacht auf Neurosyphilis wird eine Lumbalpunktion durchgeführt, um CSF für die Analyse zu gewinnen. Die CSF-Untersuchung hilft bei der Erkennung von syphilisbedingten neurologischen Komplikationen.
● Dunkelfeldmikroskopie: Die Dunkelfeldmikroskopie ist eine direkte Methode zum Nachweis von Treponema pallidum-Bakterien aus Proben, die aus Schankerstellen oder Hautläsionen entnommen wurden.
● Bildgebende Untersuchungen: Bildgebende Untersuchungen wie Ultraschall können während der Schwangerschaft durchgeführt werden, um den Fötus auf angeborene Syphilis zu untersuchen.
Es ist wichtig zu beachten, dass bei einigen Tests, insbesondere bei nicht-treponemalen Tests, falsch positive Ergebnisse auftreten können. Daher sind Bestätigungstests erforderlich, um eine genaue Diagnose der frühen Syphilis zu stellen.
Therapie und Behandlungen
Eine frühe Syphilis erfordert eine sofortige und angemessene Behandlung, um die Infektion zu beseitigen, das Fortschreiten der Krankheit zu verhindern und das Risiko von Komplikationen zu verringern. Die Behandlung wird in der Regel von medizinischem Fachpersonal durchgeführt, das Erfahrung in der Behandlung sexuell übertragbarer Infektionen hat.
Antibiotikatherapie:
Die primäre Behandlungsmethode für eine frühe Syphilis ist eine Antibiotikatherapie. Penicillin ist aufgrund seiner hohen Wirksamkeit und Effizienz nach wie vor das bevorzugte Antibiotikum für die meisten Fälle von Syphilis. Die spezifische Art und Dosierung des Penicillins hängt vom Stadium und Schweregrad der Infektion ab.
● Primäre Syphilis: Bei Personen, bei denen eine primäre Syphilis diagnostiziert wurde oder die sich innerhalb eines Jahres nach der Infektion befinden, reicht in der Regel eine einzige intramuskuläre Penicillin-Injektion aus, um die Infektion zu heilen. Die Dosis wird je nach Stadium der Schwangerschaft und eventuellen Allergien gegen Penicillin angepasst.
● Sekundäre Syphilis: Personen mit sekundärer Syphilis benötigen in der Regel eine längere Antibiotikabehandlung. Zur wirksamen Bekämpfung der Infektion werden drei Wochen lang einmal wöchentlich intramuskuläre Penicillininjektionen verabreicht.
Alternativen zu Penicillin:
Bei Patienten mit einer bekannten Penicillinallergie können alternative Antibiotika verschrieben werden. Bei nicht schwangeren Personen können Tetracyclin oder Doxycyclin zwei Wochen lang oral eingenommen werden. Diese Alternativen können jedoch eine etwas geringere Heilungsrate als Penicillin aufweisen.
Behandlung der Neurosyphilis:
Bei Neurosyphilis, bei der das zentrale Nervensystem betroffen ist, wird über einen Zeitraum von 10 bis 14 Tagen intravenös Penicillin verabreicht.
Nachsorge und Überwachung:
Nach Abschluss der Antibiotikatherapie wird den Patienten empfohlen, sich zur Beurteilung und Überwachung der Wirksamkeit der Behandlung an ihren Arzt zu wenden. Dies kann wiederholte Blutuntersuchungen zur Überprüfung des Rückgangs der Syphilis-Antikörper umfassen.
Partnermanagement:
Patienten, bei denen eine Syphilis im Frühstadium diagnostiziert wurde, sollten ihre Sexualpartner über die Infektion informieren und sie dazu ermutigen, sich ärztlich untersuchen und angemessen behandeln zu lassen. Die Benachrichtigung und Untersuchung der Partner sind unerlässlich, um eine weitere Übertragung zu verhindern.
Überlegungen zur Schwangerschaft:
Schwangere Frauen mit Syphilis erfordern besondere Aufmerksamkeit. Eine angemessene Behandlung während der Schwangerschaft kann eine angeborene Syphilis verhindern und die Gesundheit des Fötus gewährleisten. Penicillin ist die bevorzugte Behandlung für schwangere Patientinnen, wobei der Behandlungsplan je nach Stadium der Syphilis und Schwangerschaftstrimester variieren kann.
Ansprechen auf die Behandlung:
Die meisten Personen sprechen gut auf die Antibiotikabehandlung an, wobei die Geschwüre innerhalb weniger Wochen abheilen und der Hautausschlag verschwindet. Das Abklingen der Symptome garantiert jedoch nicht die vollständige Ausheilung der Infektion. Eine engmaschige Nachsorge und kontinuierliche Überwachung sind entscheidend für den Erfolg der Behandlung.
Eine frühzeitig erkannte Syphilis ist mit einer geeigneten Antibiotikatherapie gut heilbar, was die Bedeutung einer ärztlichen Behandlung und der Einhaltung des verschriebenen Behandlungsplans unterstreicht. Gesundheitsdienstleister spielen eine wichtige Rolle bei der umfassenden Therapie und der erfolgreichen Behandlung dieser sexuell übertragbaren Infektion.
Ursachen und Risikofaktoren
Das Verständnis der Ursachen und Risikofaktoren der frühen Syphilis ist entscheidend für die Prävention ihrer Übertragung und die Ausrichtung von Strategien im Bereich der öffentlichen Gesundheit. In diesem Abschnitt werden die direkten Ursachen der Krankheit und die biologischen Prozesse untersucht, die bei einer Infektion ablaufen. Darüber hinaus werden die verschiedenen Risikofaktoren untersucht, die die Wahrscheinlichkeit einer Ansteckung mit Syphilis erhöhen.
Ursachen:
Die frühe Syphilis wird in erster Linie durch eine Infektion mit dem Bakterium Treponema pallidum verursacht. Die Übertragung der Bakterien erfolgt durch direkten Kontakt mit infektiösen Wunden oder Schleimhäuten einer infizierten Person während sexueller Aktivitäten. Die Bakterien gelangen über winzige Risse oder Abschürfungen in der Haut oder den Schleimhäuten in den Körper, was ihre Invasion und anschließende Verbreitung erleichtert.
Nach dem Eindringen in den Körper beginnt Treponema pallidum sich zu vermehren und über die Blutbahn und das Lymphsystem zu verbreiten, was zur Bildung von primären Syphilis-Geschwüren an der Infektionsstelle führt. Diese schmerzlosen Geschwüre enthalten eine hohe Konzentration der Bakterien und sind hochansteckend, sodass sie eine wichtige Quelle für die Übertragung auf andere Personen darstellen.
Mit fortschreitender Infektion zur sekundären Syphilis breitet sich das Bakterium auf verschiedene Organe und Gewebe aus, was zu systemischen Symptomen und Manifestationen führt, darunter der charakteristische Hautausschlag. Das Immunsystem reagiert mit einer Immunantwort auf die Infektion, was zum Auftreten klinischer Symptome im Zusammenhang mit der frühen Syphilis führt.
Risikofaktoren:
Mehrere Risikofaktoren tragen zur Wahrscheinlichkeit einer Ansteckung mit einer frühen Syphilis bei:
● Ungeschützter Geschlechtsverkehr: Ungeschützter Geschlechtsverkehr, einschließlich Vaginal-, Anal- und Oralsex, mit einem infizierten Partner erhöht das Risiko, sich mit Syphilis anzustecken.
● Mehrere Sexualpartner: Mehrere Sexualpartner oder risikoreiches Sexualverhalten erhöhen die Wahrscheinlichkeit, mit einer infizierten Person in Kontakt zu kommen.
● Männer, die Sex mit Männern haben (MSM): MSM haben aufgrund der höheren Prävalenz der Infektion in dieser Bevölkerungsgruppe ein erhöhtes Risiko für eine Syphilis-Übertragung.
● STI-Vorgeschichte: Personen mit anderen sexuell übertragbaren Infektionen in der Vorgeschichte können ein erhöhtes Risiko für eine Syphilis-Infektion haben.
● Drogenmissbrauch: Drogen- und Alkoholkonsum kann das Urteilsvermögen und die Entscheidungsfähigkeit beeinträchtigen und zu risikoreicherem Sexualverhalten führen.
● Schwangerschaft: Schwangere Frauen mit Syphilis können die Infektion auf ihr ungeborenes Kind übertragen, was zu einer angeborenen Syphilis führen kann.
● Geografische Lage: Die Syphilis-Raten können je nach geografischer Region variieren, wobei in bestimmten Gebieten eine höhere Prävalenz auftritt.
● Altersgruppe: Bestimmte Altersgruppen, wie z. B. junge Erwachsene, können höhere Syphilis-Infektionsraten aufweisen.
Die Identifizierung und Bekämpfung dieser Risikofaktoren ist unerlässlich, um die Ausbreitung der frühen Syphilis zu verhindern und Maßnahmen zur öffentlichen Gesundheit zur Bekämpfung der Krankheit zu fördern.
Verlauf der Krankheit und Prognose
Das Verständnis des Verlaufs der frühen Syphilis und ihrer Prognose ist für eine rechtzeitige Intervention und Behandlung unerlässlich. Dieser Abschnitt gibt Einblicke in den typischen Verlauf der Krankheit, ihre Stadien und den allgemeinen Zeitrahmen für das Fortschreiten der Krankheit. Darüber hinaus wird eine umfassende Prognose skizziert, in der mögliche Ergebnisse und Auswirkungen für die betroffenen Personen hervorgehoben werden.
Verlauf der Erkrankung:
Die frühe Syphilis verläuft in drei Stadien: Primäre Syphilis, Sekundäre Syphilis und frühe latente Syphilis. Der zeitliche Verlauf und die Symptome können individuell variieren, aber im Allgemeinen verläuft die Erkrankung wie folgt:
● Primäre Syphilis: Das primäre Stadium beginnt mit dem Auftreten einer schmerzlosen, runden Wunde, die als Schanker bezeichnet wird, an der Infektionsstelle. Schanker entwickeln sich in der Regel innerhalb von 3 Wochen bis 3 Monaten nach der Ansteckung. Der Schanker ist hochansteckend und kann aufgrund seiner Schmerzlosigkeit unbemerkt bleiben. Er heilt in der Regel innerhalb von 3 bis 6 Wochen ohne Behandlung ab, auch wenn die Infektion fortbesteht und fortschreitet.
● Sekundäre Syphilis: Die sekundäre Syphilis tritt in der Regel innerhalb von 2 bis 10 Wochen nach dem Verschwinden des primären Schankers auf. In diesem Stadium verbreitet sich das Bakterium über die Blutbahn und das Lymphsystem im gesamten Körper und führt zu einer systemischen Infektion. Das charakteristische Merkmal der sekundären Syphilis ist ein typischer Hautausschlag, der an den Handflächen, Fußsohlen und anderen Körperstellen auftreten kann. Weitere Symptome sind Fieber, Müdigkeit, Halsschmerzen und geschwollene Lymphknoten. Die Symptome der sekundären Syphilis können innerhalb weniger Wochen spontan abklingen, aber ohne Behandlung bleibt die Infektion latent und kann zum nächsten Stadium fortschreiten.
● Frühe latente Syphilis: Nach der sekundären Syphilis treten die Betroffenen in das frühe latente Stadium ein. Während dieser Zeit gibt es keine sichtbaren Symptome, aber die Infektion bleibt im Körper latent vorhanden. Die frühe latente Syphilis umfasst den Zeitraum innerhalb des ersten Jahres nach der Erstinfektion. Nach dieser Phase können die Betroffenen in die späte latente Syphilis übergehen oder eine tertiäre Syphilis entwickeln, wenn sie nicht behandelt werden.
Prognose:
Die Prognose der frühen Syphilis ist bei rechtzeitiger Diagnose und Behandlung im Allgemeinen günstig. Eine Antibiotikatherapie, insbesondere mit Penicillin, ist hochwirksam, um die Infektion zu heilen und ein weiteres Fortschreiten der Krankheit zu verhindern. Personen, die in einem frühen Stadium rechtzeitig behandelt werden, haben eine ausgezeichnete Prognose, wobei bei den meisten die Symptome vollständig abklingen und das Fortschreiten der Krankheit gestoppt wird.
Ohne angemessene Behandlung kann die frühe Syphilis jedoch zu einer späten latenten Syphilis oder einer tertiären Syphilis fortschreiten. Die späte latente Syphilis bezeichnet Fälle, in denen die Infektion zwar symptomfrei bleibt, aber über das erste Jahr nach der Erstinfektion hinaus fortbesteht. Die tertiäre Syphilis hingegen ist ein schweres und potenziell lebensbedrohliches Stadium, das sich Jahre oder sogar Jahrzehnte nach der Erstinfektion entwickeln kann.
In der tertiären Syphilis kann das Bakterium verschiedene Organe, darunter Herz, Gehirn, Nerven, Knochen und Blutgefäße, schwer schädigen. Dieses Stadium kann zu schwerwiegenden Komplikationen führen, wie z. B. Neurosyphilis (Befall des zentralen Nervensystems), kardiovaskuläre Syphilis (Befall des Herzens und der Blutgefäße) und gummatöse Syphilis (Bildung zerstörerischer Läsionen im Gewebe).
Eine frühzeitige Erkennung, eine angemessene Antibiotikabehandlung und regelmäßige Nachuntersuchungen sind entscheidend für eine positive Prognose und die Vermeidung langfristiger Folgen einer unbehandelten frühen Syphilis.
Prävention
Prävention spielt eine entscheidende Rolle bei der Eindämmung der Übertragung und Ausbreitung der frühen Syphilis. Dieser Abschnitt bietet einen umfassenden Überblick über verschiedene Präventionsmethoden, darunter Strategien für Einzelpersonen zur Verringerung ihres Infektionsrisikos und Maßnahmen im Bereich der öffentlichen Gesundheit zur Eindämmung der Prävalenz.
Sichere Sexualpraktiken:
Durch sicheren Sex mit konsequenter und korrekter Verwendung von Kondomen bei jedem Geschlechtsverkehr kann das Risiko, sich mit Syphilis und anderen sexuell übertragbaren Infektionen (STIs) anzustecken, erheblich gesenkt werden. Dies ist besonders wichtig für Personen, die mehrere Sexualpartner haben oder risikoreiche Sexualpraktiken ausüben.
Routinemäßige Tests und Vorsorgeuntersuchungen:
Regelmäßige Tests und Vorsorgeuntersuchungen auf Syphilis sind unerlässlich, insbesondere für Personen mit mehreren Sexualpartnern oder solche, die risikoreiche Sexualpraktiken ausüben. Eine frühzeitige Erkennung der Infektion ermöglicht eine schnelle Behandlung und verringert das Risiko einer Übertragung auf andere.
Benachrichtigung von Partnern und Kontaktverfolgung:
Die Information der Sexualpartner über eine Syphilis-Diagnose und die Aufforderung, sich testen und behandeln zu lassen, kann dazu beitragen, eine weitere Übertragung der Infektion innerhalb sexueller Netzwerke zu verhindern. Die Gesundheitsbehörden führen häufig Kontaktverfolgungen durch, um potenziell exponierte Personen zu identifizieren und zu benachrichtigen.
Präexpositionsprophylaxe (PrEP):
PrEP ist ein Präventivmedikament für Personen mit hohem Risiko, sich mit HIV zu infizieren. Es schützt zwar nicht vor Syphilis, kann jedoch das Risiko einer HIV-Übertragung verringern, die häufig mit risikoreichem Sexualverhalten verbunden ist.
Aufklärungs- und Sensibilisierungsprogramme:
Die Aufklärung über Syphilis, ihre Symptome und Übertragungswege ist entscheidend für die Förderung eines verantwortungsvollen Sexualverhaltens und die Ermutigung zu frühzeitigen Tests und Behandlungen. Aufklärungskampagnen können auch Stigmatisierungen im Zusammenhang mit sexuell übertragbaren Infektionen thematisieren und einen offeneren und informierteren Dialog über sexuelle Gesundheit fördern.
Untersuchungen bei Schwangeren:
Routinemäßige Syphilis-Untersuchungen während der Schwangerschaftsvorsorge sind für Schwangere unerlässlich, um Syphilis frühzeitig zu erkennen und zu behandeln. Eine rechtzeitige Behandlung kann die Übertragung auf das ungeborene Kind verhindern und das Risiko einer angeborenen Syphilis verringern.
Tests auf andere STIs:
Regelmäßige Tests auf andere STIs wie HIV und Gonorrhö sind wichtig, da Personen, die mit einer STI infiziert sind, ein höheres Risiko haben, sich mit Syphilis anzustecken oder sie auf andere zu übertragen.
Zugang zur Gesundheitsversorgung sicherstellen:
Die Verbesserung des Zugangs zu Gesundheitsdiensten, einschließlich STI-Tests und -Behandlungen, ist von entscheidender Bedeutung, um gefährdete Bevölkerungsgruppen zu erreichen und eine rechtzeitige Diagnose und Behandlung von Syphilis sicherzustellen.
Gemeindearbeit und Unterstützung:
Gemeindebasierte Organisationen und Aufklärungsarbeit können eine wichtige Rolle dabei spielen, gefährdete Bevölkerungsgruppen zu erreichen, Ressourcen bereitzustellen und den Zugang zu Test- und Behandlungsangeboten zu erleichtern.
Durch die Kombination dieser Präventionsmaßnahmen und die Umsetzung umfassender Strategien im Bereich der öffentlichen Gesundheit ist es möglich, die Häufigkeit von Syphilis im Frühstadium zu reduzieren, die Früherkennung und Behandlung zu verbessern und letztendlich auf die Eindämmung und Ausrottung der Krankheit hinzuarbeiten.
Zusammenfassung
Die frühe Syphilis ist eine sexuell übertragbare Infektion, die durch das Bakterium Treponema pallidum verursacht wird. Die Krankheit verläuft in mehreren Stadien, die sich in Primär-, Sekundär- und frühe Latenzstadien unterteilen. Eine rechtzeitige Diagnose und Behandlung mit Antibiotika, insbesondere Penicillin, sind für eine günstige Prognose und zur Vorbeugung von Komplikationen unerlässlich. Prävention spielt eine entscheidende Rolle bei der Eindämmung der Ausbreitung der frühen Syphilis. Zu den wichtigsten Präventionsstrategien gehören sichere Sexualpraktiken, Routinetests, Partnerbenachrichtigung, Gesundheitsaufklärung und Aufklärungsarbeit in der Bevölkerung. Früherkennung, verantwortungsbewusstes Sexualverhalten und Zugang zu Gesundheitsdiensten sind von größter Bedeutung. Die frühe Syphilis kann mit einer sofortigen medizinischen Intervention wirksam behandelt werden. Durch proaktive Maßnahmen können Einzelpersonen ihre Gesundheit und die Gesundheit ihrer Partner schützen.